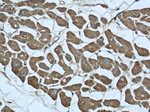
MYOM1 Antibody in Immunohistochemistry (Paraffin) (IHC (P))

Search
Proteintech
MYOM1 Polyclonal Antibody
{{$productOrderCtrl.translations['antibody.pdp.commerceCard.promotion.promotions']}}
{{$productOrderCtrl.translations['antibody.pdp.commerceCard.promotion.viewpromo']}}
{{$productOrderCtrl.translations['antibody.pdp.commerceCard.promotion.promocode']}}: {{promo.promoCode}} {{promo.promoTitle}} {{promo.promoDescription}}. {{$productOrderCtrl.translations['antibody.pdp.commerceCard.promotion.learnmore']}}
产品信息
20360-1-AP
种属反应
已发表种属
宿主/亚型
分类
类型
抗原
偶联物
形式
浓度
规格
纯化类型
保存液
内含物
保存条件
运输条件
产品详细信息
The antibody is specific to MYOM1.
靶标信息
The giant protein titin, together with its associated proteins, interconnects the major structure of sarcomeres, the M bands and Z discs. The C-terminal end of the titin string extends into the M line, where it binds tightly to M-band constituents of apparent molecular masses of 190 kD (myomesin 1) and 165 kD (myomesin 2). This protein, myomesin 1, like myomesin 2, titin, and other myofibrillar proteins contains structural modules with strong homology to either fibronectin type III (motif I) or immunoglobulin C2 (motif II) domains. Myomesin 1 and myomesin 2 each have a unique N-terminal region followed by 12 modules of motif I or motif II, in the arrangement II-II-I-I-I-I-I-II-II-II-II-II. The two proteins share 50% sequence identity in this repeat-containing region. The head structure formed by these 2 proteins on one end of the titin string extends into the center of the M band. The integrating structure of the sarcomere arises from muscle-specific members of the superfamily of immunoglobulin-like proteins. Alternatively spliced transcript variants encoding different isoforms have been identified.
仅用于科研。不用于诊断过程。未经明确授权不得转售。
生物信息学
蛋白别名: 190 kDa connectin-associated protein; 190 kDa titin-associated protein; EH-myomesin; myomesin (M-protein) 1 (190kD); myomesin 1 (skelemin) 185kDa; myomesin 1, 185kDa; Myomesin family member 1; Myomesin-1; Skelemin; unnamed protein product
基因别名: D430047A17Rik; MYOM1; SKELEMIN
UniProt ID: (Human) P52179, (Mouse) Q62234
Entrez Gene ID: (Human) 8736, (Mouse) 17929, (Rat) 316740